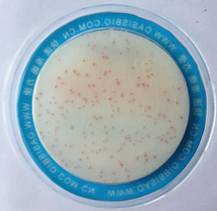
产品细节图片1

万千商家帮你免费找货
0 人在求购买到急需产品
- 详细信息
- 文献和实验
- 技术资料
- 库存:
119
- 保质期:
1年
- 供应商:
上海机纯实业有限公司
- 保存条件:
低温保存
- 规格:
盒
用途: 菌落总数的测定
产品详细介绍
大肠菌群的测定
性能特点
1、菌落总数检测板原理及适用范围
菌落总数是指样品经过处理,在一定条件下培养后所得1 mL(g)检样或单位面积样品中所含菌落的总数,是常用的微生物检测项目。菌落总数检测板是一种预先制备的一次性培养基产品,含有标准的营养培养基,吸水凝胶和脱qing酶指示剂氯化三苯基四氮唑(TTC),菌落在检测板上呈红色,这样可缩短计数时间和增强计数效果。本产品适合于各类食品及食品原料中菌落总数的测定。执行标准:《食品安全国家标准 食品微生物学检验 菌落总数测定》(GB 4789.2)。
2、操作方法
2.1 样品处理:取样品 25 mL(g)放入含有225 mL灭菌磷酸缓冲稀释液(或生理盐水)的取样罐或均质袋内,制成1:10的样品匀液,必要时用1 mol/LNaOH或1mol/L HCl溶液调节样品匀液pH至6.6~7.2。用1mL灭菌吸管吸取1:10稀释液1 mL,注入含有9 mL稀释液的试管内,振摇后成为1:100的样品匀液,以此类推,做出1:1000等稀释度的样品匀液,每次换一支吸管。
2.2 接种:一般食品选2~3个稀释度进行检测,含菌量少的液体样品(如饮用纯水和矿泉水等)可直接吸取原液进行检测。将菌落总数检测板置于平坦实验台面,揭开上层膜,用无菌吸管吸取1 mL样品匀液滴加到检测板内,迅速贴上层膜并水平晃动检测板,让样品匀液均匀吸附在滤纸上,静置10s左右,待样品匀液完全被吸附在滤纸上。每个稀释度接种两片。同时做一片空白阴性对照。
2.3 培养:将检测板叠在一起,倒置于恒温培养箱内。一般食品培养温度为36℃±1℃,培养15~24 h;水产品培养温度为30℃±1℃,培养48 h。
3、菌落总数检测板结果判读
细菌在检测板上生长后会显示红色斑点,选择菌落数适中(30~300 CFU)的检测板进行计数,乘以稀释倍数后即为每毫升(或每克)样品中所含的细菌菌落总数。
4、计数原则及报告方式
4.1 若只有一个稀释度检测板上的菌落数在适宜计数范围内,计算两个检测板菌落数的平均值,再将平均值乘以相应稀释倍数,作为每克(或毫升)样品中菌落总数结果。
4.2 若有两个连续稀释度的检测板菌落数在适宜计数范围内时,按式(1)计算:
式中:
N——样品中菌落数;
∑C——检测板上(含适宜范围菌落数的测试片)菌落数之和;
n1——稀释度(低稀释倍数)检测板数;
n2——第二稀释度(高稀释倍数)检测板数;
d——稀释因子(稀释度)。
示例:

上述数据经“四舍五入”后,表示25000或2.5×104。
4.3 若所有的稀释度菌落总数均大于300 CFU,则对稀释度的检测板进行计数,其他检测板可记录为多不可计,结果按平均菌落数乘以稀释倍数计算。
4.4 若所有的稀释度菌落总数均小于30 CFU,则应按稀释度低的平均菌落数乘以稀释倍数计算。
4.5 若所有的稀释度(包括液体样品原液)均无菌落生长,则以小于1乘以低稀释倍数计算。
4.6 若所有稀释度的平均菌落数均不在30 CFU~300 CFU之间,其中一部分小于30 CFU或大于300CFU,则以接近30 CFU或300 CFU的平均菌落数乘以稀释倍数计算。
4.7 菌落总数的报告
4.7.1 菌落总数在100 CFU以内时,按“四舍五入”原则修约,采用两位有效数字报告。
4.7.2 大于或等于100 CFU时,第三位数字采用“四舍五入”原则修约后,取前两位数字,后面的0代替位数,也可用指数形式来表示,按“四舍五入”原则修约后,采用两位有效数字。
4.7.3 若测试片上一片红色无法计数时,则报告多不可计。
4.7.4 若空白对照上有菌落生长,则此次检测结果无效。
4.7.5 固体样品以CFU/g为单位报告,液体样品以CFU/mL为单位报告。
5、菌落总数检测板附加说明
5.1 菌落总数检测板检测结果与传统平板计数琼脂平板法符合率可达90%以上。
5.2 磷酸缓冲液稀释液的配制与灭菌:贮存液:称取34.0 g分析纯磷酸二qing钾(KH2PO4)溶于500 mL蒸馏水或纯净水中,用大约175 mL的1 mol/Lqingyang化钠(NaOH)溶液调节PH至7.2,用蒸馏水稀释至1000 mL后贮存于冰箱。稀释液:取贮存液1.25 mL,用蒸馏水稀释至1000 mL,分装于适宜容器中,121℃高压灭菌15 min,或放入消毒碗柜中消毒。
5.3 生理盐水的配制与灭菌:取8.5 g分析纯氯化钠(NaCl)溶解到1000 mL蒸馏水或纯净水中,分装于适宜容器中,121℃高压灭菌15 min,或放入消毒碗柜中消毒。
5.4 注意使用过的检测板上带有活菌,需及时按照生物安全废弃物处理原则进行处理。
风险提示:丁香通仅作为第三方平台,为商家信息发布提供平台空间。用户咨询产品时请注意保护个人信息及财产安全,合理判断,谨慎选购商品,商家和用户对交易行为负责。对于医疗器械类产品,请先查证核实企业经营资质和医疗器械产品注册证情况。
 文献和实验
文献和实验标准平板培养计数法虽是国家制定的菌落总数测定方法,在一定程度上能反映食品的卫生质量,但是对一些食品却不能做出准确的评价,这是因为细菌的适应生长的温度有高温、中温和低温之分,所需的pH值和营养条件也不尽相同,并且和培养时间也有关系。例如,引起新鲜鱼类、贝类食品的新鲜度降低以至于腐败变质,起主要作用的细菌类群是低温细菌,为了调查这类食品新鲜度的状况,就必须采取低温培养72h。又如,冰冻鲜鱼、贝类作为食品原料,也常以测定嗜冷细菌的多少,来有效地反映出它们的新鲜度;再如,罐装食品,就必须以测定嗜
食品中菌落总数的测定,目的在于了解食品在生产中,从原料加工到成品包装受外界污染的情况;也可以应用这一方法观察细菌在食品中繁殖的动态,确定食品的保存期,以便对被检样品进行卫生学评价时提供依据。 食品有可能被多种类群的微生物所污染,每种细菌都有它一定的生理特性,培养时应用不同的营养条件及其生理条件(如温度、培养时间、PH值、需氧性质等)去满足其要求,才能分别将各种细菌培养出来。但在实际工作中,一般都只用一种常用的方法去作菌落总数的测定,所得结果,只包括一群能在营养琼脂上发育的嗜中温性需氧
一、菌落总数介绍: 菌落是指细菌在固体培养基上生长繁殖而形成的能被肉眼识别的生长物,它是由数以万计相同的细菌集合而成。当样品被稀释到一定程度,与培养基混合,在一定培养条件下,每个能够生长繁殖的细菌细胞都可以在平板上形成一个可见的菌落。 菌落总数就是指在一定条件下(如需氧情况、营养条件、pH、培养温度和时间等)每克(每毫升)检样所生






